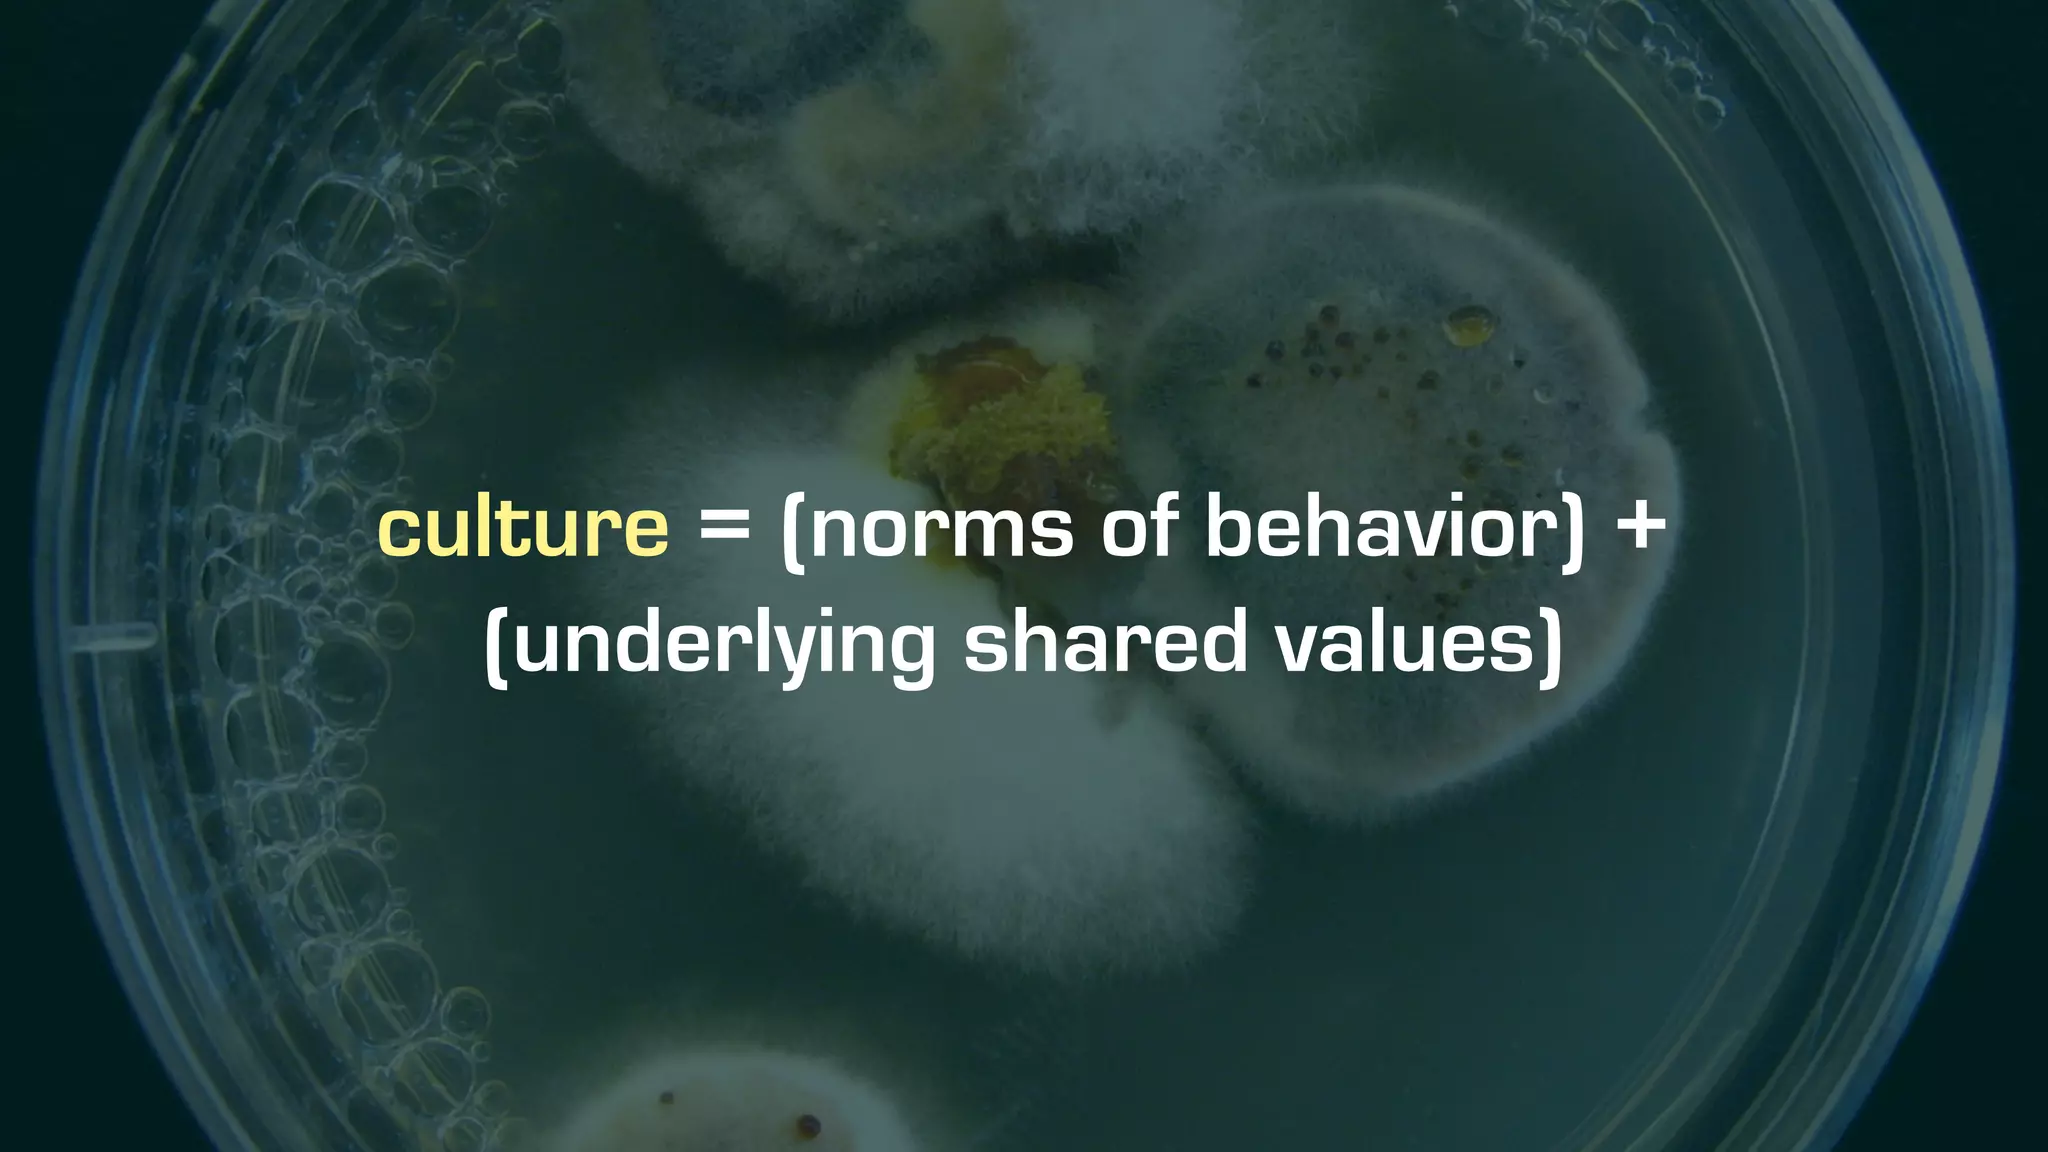
culture = (norms of behavior) +
(underlying shared values)

Bill Scott discusses the cultural and engineering transformations at PayPal that enabled significant improvements in software development, shifting from a risk-averse environment to one focused on rapid experimentation and customer feedback. Key strategies included fostering a collaborative mindset, embracing challenges, and democratizing engineering processes to encourage innovation. The transformation led to an increase in applications and a notably improved technology stack, aligning with best practices from companies like Netflix.